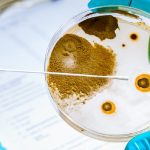

Yes, just like humans, dogs can also get kennel cough multiple times in their lifetime. However, that doesn’t mean that they will necessarily get it every time they are exposed to … [Read more...]
Dog Health - Pet Help Reviews UK
Can Dogs Get Lice?
Yes, dogs can get lice. Just like humans, dogs can be infected with lice if they come in contact with an infected animal or person. Lice are small insects that live on the skin and … [Read more...]
Can Dogs Get Listeria?
Yes, dogs can get listeriosis from the bacterium Listeria monocytogenes. It is a rare infection but can be serious. Listeria infections in dogs present a concern for pet owners due … [Read more...]
Can Dogs Get Mastitis?
Yes, dogs can get mastitis. It is an inflammation of the mammary glands usually seen in nursing dogs. Mastitis in dogs can be a serious condition requiring prompt attention, … [Read more...]
Can Dogs Get Meningitis?
Yes, dogs can get meningitis. It is an inflammation of the protective membranes covering the brain and spinal cord. Meningitis in dogs can lead to severe health complications, and … [Read more...]